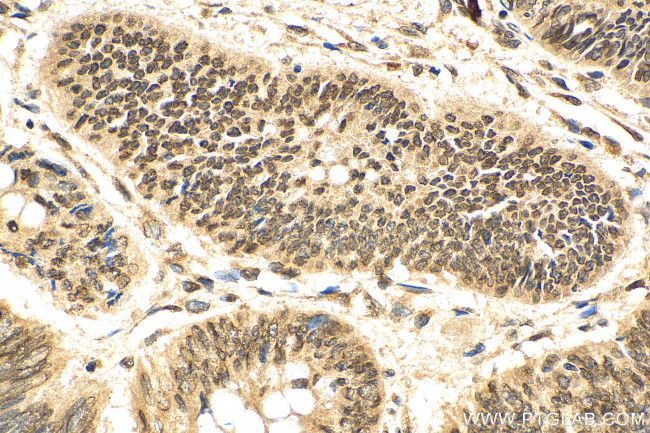
CRM1 Antibody in Immunohistochemistry (Paraffin) (IHC (P))

Search
Proteintech
CRM1 Polyclonal Antibody
{{$productOrderCtrl.translations['antibody.pdp.commerceCard.promotion.promotions']}}
{{$productOrderCtrl.translations['antibody.pdp.commerceCard.promotion.viewpromo']}}
{{$productOrderCtrl.translations['antibody.pdp.commerceCard.promotion.promocode']}}: {{promo.promoCode}} {{promo.promoTitle}} {{promo.promoDescription}}. {{$productOrderCtrl.translations['antibody.pdp.commerceCard.promotion.learnmore']}}
产品信息
27917-1-AP
种属反应
宿主/亚型
分类
类型
抗原
偶联物
形式
浓度
规格
纯化类型
保存液
内含物
保存条件
运输条件
产品详细信息
Aliquoting is unnecessary for -20°C storage.
靶标信息
Exportin - 1 (XPO1) mediates the nuclear export of cellular proteins bearing a leucine-rich nuclear export signal (NES) and RNAs. In the nucleus, in association with RANBP3, XPO1 binds cooperatively to the NES on its target protein and to the GTPase RAN in its active GTP-bound form (Ran-GTP). Docking of this complex to the nuclear pore complex is mediated through binding to nucleoproteins. Upon transit of a nuclear complex into the cytoplasm, disassembling of the complex and hydrolysis of Ran-GTP to Ran-GDP cause release of the cargo from the export receptor. The directionality of the nuclear export is thought to be conferred by an asymmetric distribution of the GTP and GDP bound forms of Ran between the cytoplasm and nucleus.
仅用于科研。不用于诊断过程。未经明确授权不得转售。
生物信息学
蛋白别名: chromosome region maintenance 1 homolog; Chromosome region maintenance 1 protein homolog; CRM1; Exp1; exportin 1 (CRM1 homolog, yeast); exportin 1 (CRM1, yeast, homolog); exportin 1, CRM1 homolog; Exportin-1; exportin-1 (required for chromosome region maintenance); unnamed protein product
基因别名: AA420417; CRM-1; CRM1; emb; Exp1; XPO1
UniProt ID: (Human) O14980, (Rat) Q80U96, (Mouse) Q6P5F9
Entrez Gene ID: (Human) 7514, (Rat) 85252, (Mouse) 103573